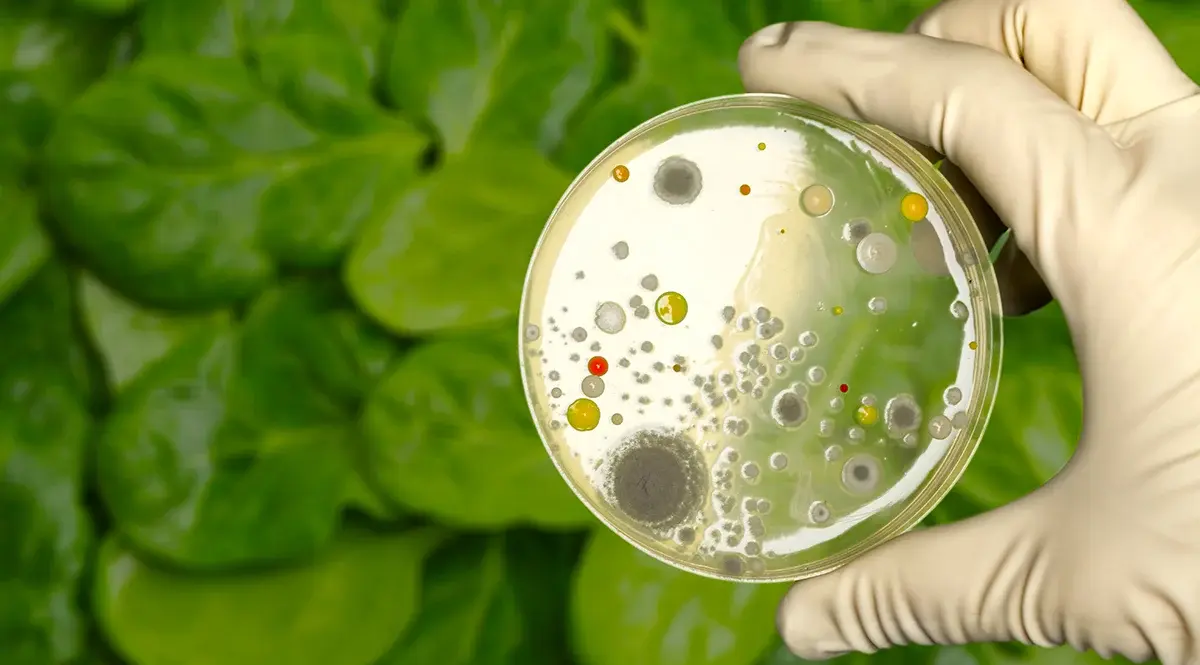

7 tendências na indústria de alimentos e bebidas que você precisa conhecer
Diante de um consumidor cada vez mais exigente, informado e conectado às questões globais, é indispensável estar por dentro das principais tendências na indústria de alimentos e bebidas.

.jpg)


